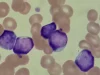
linfoblastos-wide_webp

10 hábitos diarios psicológicamente saludables, y cómo aplicarlos a tu vida
10 hábitos diarios psicológicamente saludables, y cómo aplicarlos a tu vida
Un repaso a varios hábitos psicológicamente saludables que puedes aplicar prácticamente día a día.

De la misma manera que es tarea nuestra la de proteger nuestro cuerpo y mantenerlo sano, también recae en nosotros el proteger nuestra salud mental. Son muchas las pequeñas cosas diarias que, de cumplirlas cada día, nos ayudan a disponer de un buen estado psicológico.
Son muchas las acciones que, de hacerlas diariamente, mantienen a nuestro cerebro sano, protegiendo nuestra mente y nuestro estado anímico de problemas emocionales y cognitivos, como pueden ser los fallos de memoria, los problemas de atención y los trastornos mentales.
A continuación descubriremos 10 hábitos diarios psicológicamente saludables, relacionados no únicamente con el ámbito de lo cognitivo y la ausencia de trastornos mentales, sino que también nos hacen disfrutar de unas buenas relaciones sociales.
10 hábitos diarios psicológicamente saludables, y cómo aplicarlos
Todos sabemos que la salud no es una mera cuestión física. Tanto organismos como la Organización Mundial de la Salud (OMS) y agencias sanitarias gubernamentales destacan que la salud es un estado en el que hay plenitud física, mental y social. De la misma manera que debemos proteger nuestra salud, evitando tomar sustancias dañinas para nuestro cuerpo y protegernos adecuadamente en situaciones que lo requieran (p. ej., ponerse el casco al ir en moto o llevar mascarilla en la calle) debemos también incorporar hábitos diarios psicológicamente saludables.
Que la salud psicológica no sea lo que primero veamos al vernos al espejo no significa que no repercute en nuestra forma de percibirnos y relacionarnos con los demás. Una persona agobiada emocionalmente, que no es capaz de regular sus emociones y cuyo cerebro es poco activo intelectualmente es una persona que es más vulnerable a psicopatologías varias, tanto trastornos mentales como la depresión como enfermedades neurológicas como el Alzhéimer. Para evitar esto, podemos incorporar en nuestras vidas diarias los siguientes hábitos psicológicamente saludables.
1. Mantener activo el cerebro
Cuanto más tiempo pase nuestro cerebro inactivo más nos costará arrancar. Para evitar esto es fundamental que en nuestro día a día incorporemos actividades que demanden un poco de esfuerzo mental, por muy mínimo que sea. Aunque estemos de vacaciones o disfrutemos de la jubilación es muy importante evitar que el cerebro pare porque, de hacerlo, en el momento en que tengamos que volver a trabajar o que queramos disfrutar de algo mínimamente intelectual nos va a resultar una auténtica odisea.
No hace faltar complicarse la vida ni romperse mucho la cabeza para mantener activo nuestro cerebro. Basta con recurrir a entretenimientos de toda la vida como el ajedrez, las damas, los juegos de cartas o, incluso, la petanca. Cualquier juego en el que haya un poco de estrategia puede funcionar muy bien para hacernos pensar y mantener nuestras mentes activas. También podemos recurrir a entretenimientos individuales, como el sudoku, los crucigramas, leer o escribir.
2. Plantearse metas y organizarse
Un hábito psicológicamente saludable que todos deberíamos incorporar es plantearnos metas a corto, medio y largo plazo. En el caso de los trabajadores y los estudiantes esto es especialmente importante porque, al estructurarnos nuestra rutina laboral y de estudio, siempre y cuando la cumplamos alcanzando las pequeñas metas que conforman el gran objetivo que nos hayamos planteado, evitaremos situaciones como, por ejemplo, tener que estar trabajando intensamente en el último momento.
Aunque podamos rendir intensamente en el último momento lo mejor es planear las tareas, evitando que nos agobiemos antes de tener que entregar un trabajo o estudiar para un examen porque no nos hemos sabido gestionar. El estrés que se siente en estas situaciones, aunque nos mantenga despiertos y enfocados en la meta que queremos conseguir, puede dañar nuestra salud mental y por esto, en la medida que se pueda, deberemos organizarnos nuestros objetivos.
Planearse metas y organizarse rutinas es también un potente aliado psicológico para las personas que ya están jubiladas. Debido a que aquello que organizaba su día a día, su trabajo, ya no lo tienen corren el riesgo de que los días se les pasen volando, sin saber qué hacer y entrar en una situación de apatía y depresión. Por este motivo llegados a la jubilación es muy importante plantearnos metas de cualquier tipo, ya sea aprender un idioma, mejorar en un deporte o aprender a pintar bien.
Cumpliendo los pequeños pasos que nos llevan a nuestros objetivos en cada una de estas aficiones podemos organizar mejor el tiempo, sintiendo que somos productivos y que no hemos perdido nuestra utilidad ni rendimiento.
3. Dormir suficiente
Dormir lo necesario es un factor de protección y fomento de la salud psicológica. Hay personas que necesitan dormir más que otras, pero por lo general la mayoría necesitamos dormir entre 6 y 8 horas. Dormir demasiado poco nos hace sentirnos cansandos mentalmente, poniéndonos de mal humor porque no somos capaces de hacer nuestros quehaceres diarios adecuadamente, mientras que dormir de más hace que nos cueste concentrarnos y estemos todo el día “empanados”. Hay que saber encontrar su justo equilibrio para disfrutar de una salud psicológica ideal.
4. Ser asertivo
Los hábitos que promueven una buena salud mental no son únicamente de tipo cognitivo y físico, sino también social. La asertividad es la capacidad de decir aquello que pensamos pero de forma socialmente apropiada y sin violar los derechos ni sensibilidades de los demás, pero haciendo valer los nuestros propios. Ser asertivo es un hábito que nos protege de estar de mal humor y sufrir trastornos mentales, además de mejorar nuestras relaciones sociales e identificar cuáles no valen la pena.
Dentro de esta asertividad está la capacidad de saber decir “no”, especialmente cuando las personas nos pidan más cosas de las que podemos y queremos hacer, tanto en contextos laborales como personales. Prometer más de lo que uno puede acabar agobiándonos por un lado, porque sentimos que sacrificamos nuestros deseos por los demás, y también puede hacernos quedar mal porque podemos decir “sí” a cosas que están fuera de nuestras capacidades y, por lo tanto, hacerlo mal.
5. Expresarse creativamente
El arte ha sido la herramienta de expresión emocional desde tiempos inmemoriales. Ya desde la prehistoria los humanos nos expresábamos con rupestres pinturas en las paredes de las cuevas y, a lo largo de toda la historia grandes pintores, escultores y, en definitiva, todo tipo de artistas se han lucido exponiendo su mundo interior con todo tipo de representaciones artísticas. Nosotros podemos hacer exactamente lo mismo.
Independientemente de qué técnica usemos y cuál sea nuestro talento, expresarse creativamente es una forma constructiva y muy original para mantener nuestra salud psicológica en buen estado. Ya sea con la escultura, la pintura o incluso el macramé podemos mantenernos ocupados mientras dejamos trabajar a nuestra imaginación, activando nuestro cerebro y sintiendo cómo creamos algo que representa cómo somos, algo totalmente personal e irreplicable.
6. Tener una dieta saludable
No podemos tener una buena salud mental si nos alimentamos mal. El cerebro necesita una dieta variada y balanceada para poder funcionar tanto en lo cognitivo como en lo emocional, por este motivo no podemos olvidarnos de la nutrición. Se deben incorporar alimentos de todos los grupos alimenticios, como verduras, frutas, pescados, carnes, cereales, legumbres y lácteos. También es importante controlar las porciones y asegurarse de que la dieta incorpora un 50% de carbohidratos, un 30% de grasas y un 20% de proteínas.
Entre los nutrientes que hacen que nuestro cerebro funcione mejor tenemos el omega 3 y 6, las vitaminas del grupo B (B6 y B12), el ácido fólico, el triptófano, el hierro, el calcio y el magnesio. Todos estos nutrientes se encuentran en alimentos naturales, no procesados, y prácticamente cualquier estilo de vida en el que se incorpore la dieta mediterránea tiene satisfecha la demanda de estas sustancias.
El triptófano merece especial atención puesto que es el precursor de la serotonina y la melatonina, neurotransmisores que están directamente relacionados con el estado anímico y el ciclo del sueño. Entre los alimentos que poseen triptófano encontramos las carnes magras, la yema de huevo, los lácteos, frutas como los plátanos y la piña, cereales integrales, chocolate negro y legumbres.
7. Mantenerse físicamente activo
Es un clásico lo de “mente sana en cuerpo sano”. Hacer ejercicio no únicamente nos pone en forma física, sino también mental, contribuyendo a que poseamos unas capacidades cognitivas adecuadas y un buen estado anímico. En otras palabras, la práctica de deporte regular contribuye a que tengamos buena memoria, atención, estemos protegidos de la depresión y otros trastornos mentales, además de mantenernos emocionalmente bien y ser menos susceptibles a los cambios de humor.
Lo ideal es practicar entre 3 y 4 veces a la semana algún deporte, aunque algo tan simple como es caminar unos 30 minutos al día basta para que, a la larga, nuestro estado psicológico se vea beneficiado. Cabe decir que la práctica de ejercicio más o menos intenso contribuye a que segreguemos endorfinas, las cuales nos inducen a entrar en un estado de bienestar y placer, algo que desde luego nos mantendrá de buen humor y nos hará ver la vida de una forma más positiva.
8. Desconectar un rato
En una sociedad en la que se nos pide estar conectados en todo momento pareciera que desconectar diariamente, aunque sea solo un ratito, es un imposible. Sin embargo, esto no únicamente es algo que sí es posible sino que, además, es una necesidad.
Para poder destensarnos y evitar que nuestro cerebro colapse es muy importante reservarse un momento al día, por muy breve que sea, para dejar a nuestra mente descansando, sin agobios.
Esto lo podemos hacer de muchas formas, todas las que se nos puedan venir a la cabeza. Ya sea tumbándonos en la cama escuchando música, viendo nuestro programa de televisión favorito, dándonos un baño de espuma o meditando podemos desconectar del estrés de ahí fuera, ya sea provocado por nuestra familia o por el trabajo. La mente necesita un poco de descanso sino no se puede trabajar ni rendir adecuadamente.
9. Conectar con la naturaleza
Mucha gente ignora los beneficios que nos trae la naturaleza. Pese a que llevemos siglos viviendo en ciudades, el ser humano no deja de ser un animal conectado con la naturaleza, en especial los bosques y el campo, aunque esto es también aplicable a la playa y los lagos. Sea cual sea nuestro ambiente natural favorito, cualquiera de ellos nos servirá para disponer de una buena salud mental.
Si tenemos la suerte de vivir cerca de una montaña o en el campo no podemos desaprovechar la oportunidad de darse un paseo por ahí puesto que la naturaleza nos da calma y protección frente a los problemas psicológicos. Si por el contrario no tenemos tanta suerte podemos recurrir a la alternativa de pasear por un parque o una zona verde, visitar un jardín botánico o un museo natural.
10. Cuidar las relaciones
Cuidar las relaciones personales de forma diaria es algo que pocos saben valorar, pero que todos deberíamos tener en cuenta. Puede que demos por sentado que nuestros amigos, familiares y pareja siempre estarán ahí, aunque pasen meses sin que nos hablemos por simple descuido y dejadez. Craso error. Si bien con la familia esto no pasa tanto, lo cierto es que con los amigos sí hay auténtico riesgo de que suceda y una relación que antes era como si fuéramos hermanos pasa a ser la de dos personas prácticamente desconocidas.
Por este motivo debemos dedicar un mínimo diario a reavivar nuestras relaciones sociales, sobre todo si no vivimos cerca de nuestros seres queridos. No hace falta hablar cada día con todo el mundo, pero sí dedicarles un mínimo de atención regular a cada una de las personas que forman parte de nuestra lista de contactos personales. Por ejemplo, podemos empezar el lunes hablando con un amigo, el martes con nuestro hermano, el miércoles con nuestros padres…
Si bien lo ideal es quedar en persona y hacer algo juntos, la distancia puede dificultarnos esta tarea. Afortunadamente las nuevas tecnologías nos mantienen conectados y nos acercan aquellos que están muy lejos de nosotros, con lo cual podemos hacer videollamadas o, simplemente, chatear para recordarles a aquellas personas que siguen siendo nuestros seres queridos que no nos olvidamos de ellas y que queremos mantener viva la llama del afecto y la amistad.
Referencias bibliográficas:
- Organización Mundial de la Salud (2013). Salud mental: un estado de bienestar. [Online]. Disponible en: https://www.who.int/features/factfiles/mental_health/es/.
- Ryff, C. (1989). Happiness is everything, or is it? Explorations on the meaning of psychological well-being. Journal of Personality and Social Psychology, 57, 1069 – 1081.
- Chekroud, S.R., Gueorguieva, R., Zheutlin, A.B., Paulus, M., Krumholz, H.M., Krystal, J.H. & Chekroud, A.M. (2018). Association between physical exercise and mental health in 1-,2 million individuals in the USA between 2011-2015: a cross-sectional study. The Lancet Psychiatry.
- Aranda, C., Pando, M. y Aldrete, M. G. (2002). Jubilación, trastornos psicológicos y redes sociales de apoyo en el adulto mayor jubilado. Revista de psiquiatría de la Facultad de Medicina, 29, 169 – 174.
- Belsky, J. (2001). Psicología del envejecimiento. Madrid: Paraninfo.